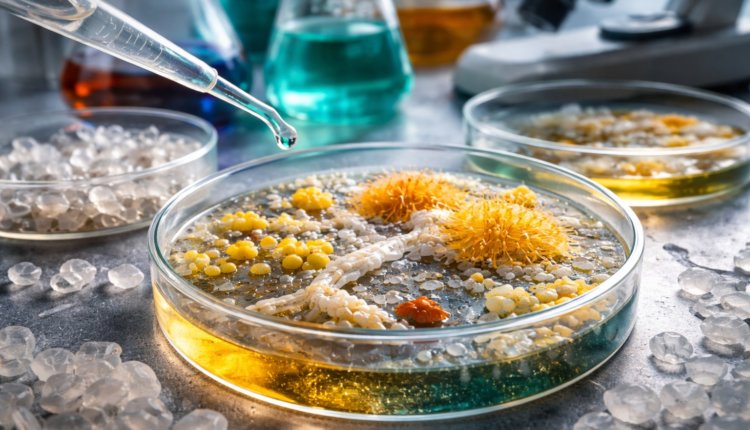

Найден микробный «консорциум», разлагающий фталаты
Метод может лечь в основу биотехнологий очистки загрязнённых территорий
Международная группа исследователей выявила синергетическое сообщество бактерий, способное эффективно разлагать фталатные пластификаторы — одни из наиболее распространённых и потенциально опасных химических компонентов пластика.
Результаты работы опубликованы в журнале Frontiers in Microbiology. Исследование показало, что отдельные микроорганизмы не способны перерабатывать такие соединения самостоятельно, однако в составе «консорциума» они демонстрируют устойчивую и эффективную деградацию загрязнителей.
Фталатные эфиры широко применяются в производстве пластмасс, включая упаковку, строительные материалы и товары повседневного использования. При этом эти вещества связывают с нарушениями гормональной системы, метаболическими сбоями и повышенными рисками развития заболеваний.
Учёные обнаружили бактерии в биоплёнке внутри лабораторного биореактора. В ходе экспериментов сформировалось устойчивое сообщество из трёх видов микроорганизмов — представителей родов Pseudomonas и Microbacterium. Вместе они смогли полностью разложить диэтилфталат — модельное соединение пластификаторов — в течение 24 часов при температуре 30°C.
Ключевым механизмом стала так называемая «перекрёстная подпитка», при которой один микроорганизм выделяет промежуточные продукты распада, а другой использует их как источник энергии. Такой обмен веществами позволяет бактериям действовать как единая система и преодолевать ограничения, характерные для отдельных видов.
Дополнительный анализ показал, что ферменты, участвующие в разложении фталатов, ранее не были описаны в науке. Кроме того, консорциум продемонстрировал способность перерабатывать не только диэтилфталат, но и другие распространённые пластификаторы, включая диметил-, дипропил- и дибутилфталаты.
Исследователи отмечают, что подобные микробные сообщества могут стать основой для новых биотехнологических решений в области очистки окружающей среды. В частности, рассматривается возможность применения таких бактерий для очистки сточных вод, содержащих микропластик и химические добавки.
В то же время ученые подчеркивают, что технология находится на ранней стадии развития. Консорциум пока не способен разлагать более устойчивые полимеры, такие как полиэтилен или полипропилен, а его эффективность в природных условиях требует дополнительной проверки.
Тем не менее открытие подтверждает, что кооперация микроорганизмов может стать ключевым фактором в разработке новых подходов к борьбе с пластиковым загрязнением. В перспективе такие решения могут быть интегрированы в системы обращения с отходами и способствовать развитию экономики замкнутого цикла.

Комментарии закрыты.